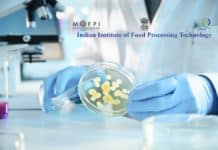
Associate Professor Vacancy in Microbio /Biotech / Food Processing @ IIFPT – Ministry of Food Processing Industries, Govt of India Govt Job @ IIFPT - Research Positions

PhD Program Announcement 2017 @ Dr. Reddy’s Institute of Life Sciences
Ph.D. PROGRAM ANNOUNCEMENT 2017
DR. REDDY’S INSTITUTE OF LIFE SCIENCES
Dr. Reddy’s Institute of Life Sciences (DRILS) is a non-profit research institute located on the...
Biotecnika Times – Newsletter 22.06.2017
CSIR NET June 2017 Answer Key with Detailed Explanation - PDF Available for Download
Official Answer key Of CSIR NET June 2017 Exam will be Out after the...
14 Scholarships for Doctoral Researchers At Konstanz Research School Chemical Biology (KoRS-CB), Germany
Konstanz Research School Chemical Biology (KoRS-CB) offers 14 scholarships for doctoral researchers. From 1 June to 15 July, the Konstanz Research School Chemical Biology...
Associate Professor Vacancy in Microbio /Biotech / Food Processing @ IIFPT – Ministry of...
Indian Institute of Food Processing Technology (IIFPT) is a national Academic and Research institute under the Ministry of Food Processing Industries, Government of India,...
WWF-India Hiring Life Science Candidates For Programme Officer – Climate Change & Energy Post
WWF-India is looking for a dynamic and motivated individual to contribute to and deliver on WWF-India’s Climate Change and Energy agenda, which focuses on...
JRF position for M.Sc/M.Tech candidates at Stem Cell Biology Laboratory, Aravind Medical Research Foundation
AMRF is a Registered Society and also recognized as a Scientific and Industrial Research Organization (SIRO) by Ministry of Science and Technology, Government of...
Biotecnika Times – Newsletter 21.06.2017
Govt Job | Bioassay Analyst / Protein Analytical Expert Vacancy With Salary of Rs. 75,000/- p.m. @ NIB
Applications are invited for following posts on...
Bacterial Classification is More Complex then We Thought
New investigation from Dartmouth College hoisted uncertainty regarding how scientists must interpret observed groupings of bacteria. The study advises forethought with the postulation that...
Israel’s Gamida Cell Manages To Gather a Whopping $40 million to Fund Its Bone...
An Israel-based company, Gamida Cell Ltd., which already has products such as CordIn® for rare genetic diseases, and NK cells as a treatment for...
This Amiable Immune Cell Acts Like A Little Activist To Protect Us !
T cell or the T lymphocyte is a type of White Blood Cell that is a vital part of our immune system and can...
Bacteria Hangouts Discovered – Check Out What Happens After You Sneeze
For all you cleanliness freaks out there, here comes your way a dreadful, cringe-worthy read.
And for the introverts, all the more reason to stay...
Eat Your Greens ! Broccoli Could Be a Weapon Against Diabetes
Wait! Flashback to the time your mum yelled the same?
Now get ready to get reprimanded again! She is now backed by Science!
These greens, Broccoli...
Photosynthetic Bacteria Prevent Cardiac Arrests in Rats
A network of blood vessels known as coronary arteries surrounds the heart muscle and supply it with blood that is rich in oxygen. The...
Admissions Open For M.sc / PG Diploma / M. Phill & PhD Courses @...
Admissions to MSc Biotechnology
Opportunity for Dual programme - PG Dip. in Analytical Techniques
or
PG Dip. in Clinical Trial and Regulatory Affairs (Industry...
ANU Excellence Scholarship Program 2017 – Applications Invited
ANU Excellence Scholarship Program
Overview
The Australian National University Excellence Scholarship is available exclusively to international students at both undergraduate and postgraduate levels.
Numerous scholarships across multiple...